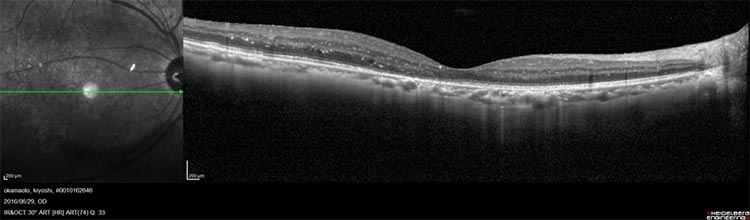
糖尿病網膜症画像

糖尿病網膜症とは
糖尿病網膜症は、糖尿病に罹患している方に発症する病気のことで、いわゆる合併症のひとつです。
血液中にはブドウ糖が含まれていて、これが細胞に取り込まれることで、主に脳のエネルギー源となっていきます。その際にインスリンという膵臓で作られるホルモンの一種が働くわけですが、これが作用不足を引き起こすとブドウ糖は血液中に残ったままとなって、血糖値(血液中に含まれるブドウ糖の濃度)は慢性的に上昇したままになってしまいます。これが糖尿病です。発症の原因としては、インスリンを作成する膵臓のβ細胞が自己免疫反応によって破壊されたことでほとんど分泌されない(Ⅰ型糖尿病)、もしくは不摂生な生活習慣の蓄積によって膵臓が疲弊し、インスリンの分泌量が少ない、あるいは効きが悪い状態となっている(Ⅱ型糖尿病)ということが挙げられますが、患者さんの大半はⅡ型糖尿病です。
糖尿病は発症しても自覚症状が現れにくい病気なので、多くの患者さんは病状を進行させることになります。さらに経過すれば、喉の異常な渇き、多尿・頻尿、全身の倦怠感、体重減少などの症状が現れるようになります。それでも放置が続けば、やがて血管障害が発生するようになるのですが、この場合は細小血管が損傷を受けやすくなります。そもそも網膜というのは、多くの細小血管が集まっている部位でもあるので、合併症を発症させやすいことから、糖尿病腎症、糖尿病神経障害と共に糖尿病三大合併症とも呼ばれています。
ちなみに糖尿病と診断されてもすぐに合併症を発症させることはありません。発症後5~10年はかかると言われています。そのため、すぐに糖尿病網膜症に関する治療を要するわけではありませんが、糖尿病の正確な発症時期がいつなのかはっきり分かる方ばかりではありませので、定期的に眼科で検査を受けるようにしてください。
-

正常な網膜 -

単純網膜症
網膜の血管の状態が悪くなると、血管から血液の成分が血管外に漏れ出します。網膜の中心である黄斑部似血液の成分が漏れて貯まると、黄斑浮腫と呼ばれる状態になり、視力が大幅に低下し、ものが歪んで見える(変視症)という症状を来します。逆に黄斑浮腫が出ない場合は、自覚症状が現れにくいです。それでも網膜の毛細血管で糖がだぶつき、これによって同血管が詰まるなどすれば、新生血管が発生し、この脆くて破れやすい血管から血液の成分が漏れる、硝子体内に出血するとなると、飛蚊症(虫が目の前で飛んでいるように見える)、視力低下、霧視などの症状がみられるようになります。さらに放置を続けると網膜表面に増殖膜が張ってきて、網膜剥離を起こし、失明することもあるので要注意です。
また、新生血管が隅角部に生じると血管新生緑内障となって、これから失明に至るケースもあります。
検査について
診断をつけるための検査としては、主に眼底検査によって、網膜の状態や出血の有無、硬性白斑、新生血管を調べるなどして、判定していきます。
治療について
病状の進行状態によって治療は異なります。この場合、糖尿病網膜症の初期(単純網膜症)、中期(増殖前網膜症)、進行期(増殖網膜症)と主に3つに分類して行っていきます。
単純網膜症の場合は、糖尿病の患者さんが行う治療が中心になります。具体的には、生活習慣の改善(食事療法や運動療法 など)や薬物療法(経口血糖降下薬)になります。主に血糖コントロールに注力し、糖尿病網膜症に対する治療をしませんが、定期的に眼科を受診するようにしてください。
また増殖前網膜症の患者さんにつきましても、黄斑部(網膜の中心)に何らかの病変がある、硝子体出血がみられるといったことが起きなければ自覚症状はみられません。この場合も血糖のコントロールの治療だけで充分なこともありますが、毛細血管の血管障害によって、新生血管が発生しているのであれば、網膜光凝固術(レーザー)によって網膜を熱凝固し、抑制していきます。

さらに進行期(増殖網膜症)の場合も新生血管の発生を防ぐ網膜光凝固術を行うほか、新生血管が破れて硝子体内で出血がみられたという場合は、濁った硝子体や増殖膜を取り除く硝子体手術を行っていきます。このほか、血糖のコントロールの治療も続けていきます。
黄斑浮腫は網膜症のどの時期でも発症する可能性がありますが、視力への影響が大きいため、早めに治療を開始します。レーザー、ステロイド・テノン嚢下注射(結膜下への注射)、抗VEGF薬の眼内注射などを行います。